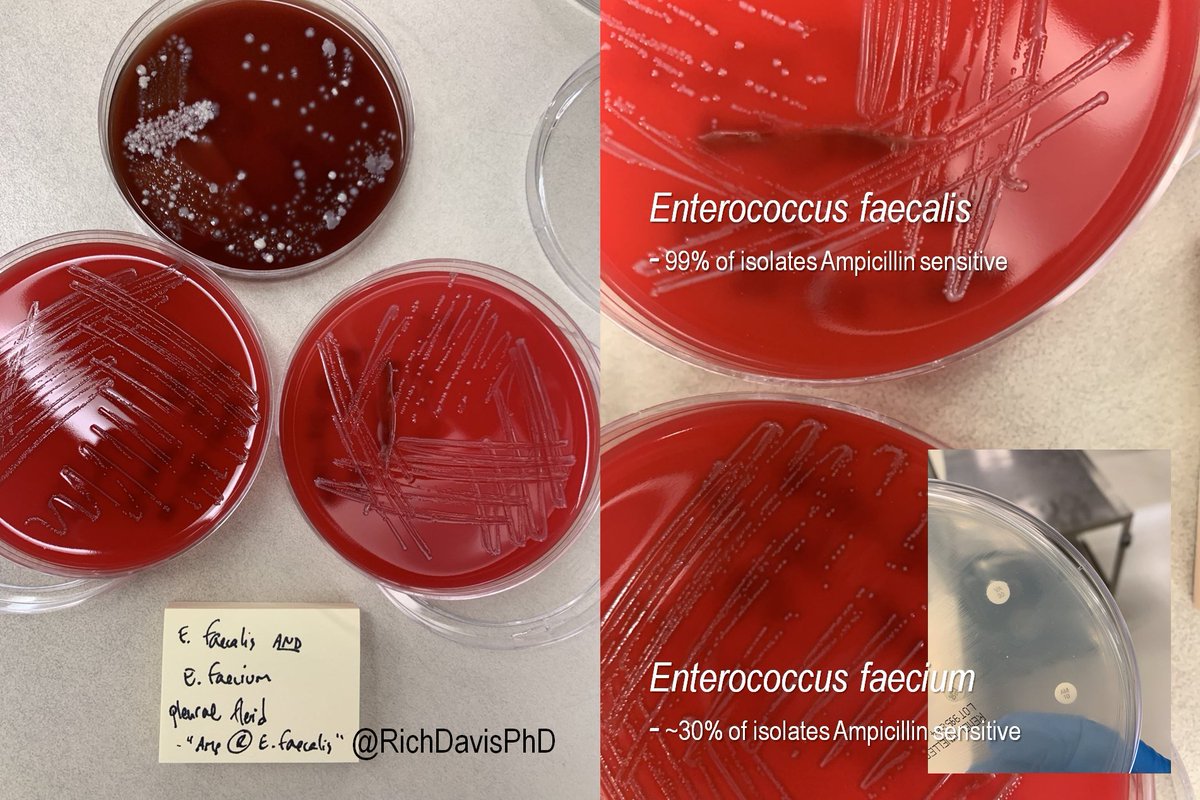
richdavisphd's tweet image. #MicroRounds (Day 847): for #LabWeek2021 #WhyClinMicroMatters and why techs matter!

Pleural fluid w/ mixed bugs. Enterococcus faecalis (~99% isolates Ampicillin S) was Amp R. Huh?

Tech knew something was off, went looking: mixed w/ resistant E. faecium! #ASMClinMicro #IDTwitter
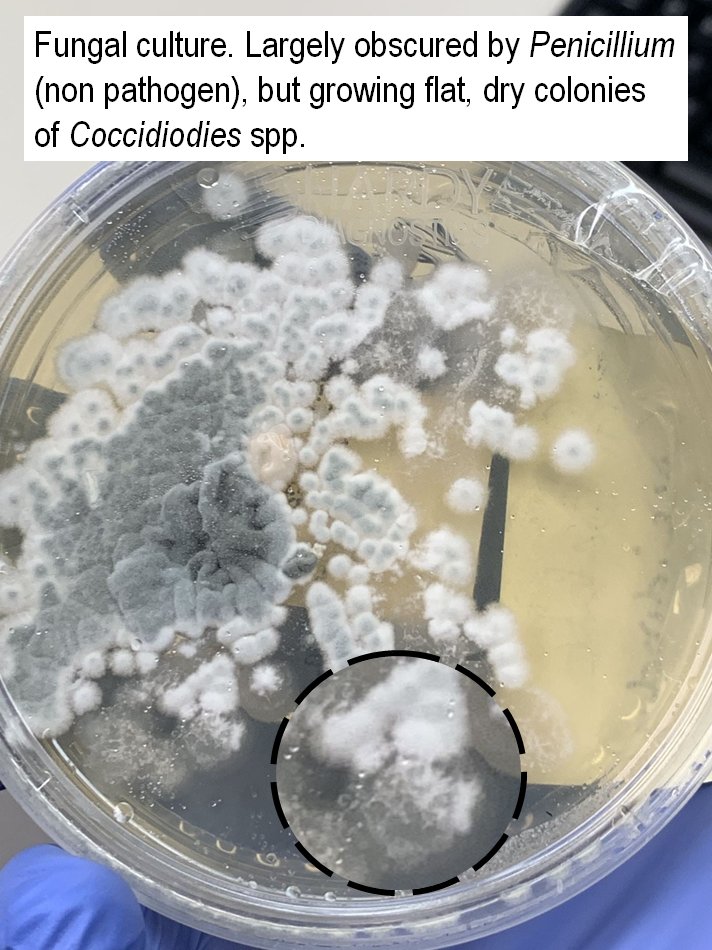
richdavisphd's tweet image. #MicroRounds (Day 843): For #LabWeek2021, I&apos;m highlighting #WhyClinMicroMatters with great catches by techs.

Fungal culture. Superficial source, lots of Penicillium. But suspicious tech looks behind it to find…

Coccidiodes spp.- a serious invasive mold #ASMClinMicro #IDTwitter

#labweek2021 risultati di ricerca
بمناسبة أسبوع مهنيي المختبرات الطبية ٢٠٢١، نشكر أبطال المختبرات على العمل الاستثنائي خلال فترة الجائحة، نحن فخورون بكم. #LabWeek2021 #LabWeek

This past year, the fight against COVID-19 brought the importance of lab medicine professionals into the spotlight. AACC is proud of the hard work and ingenuity our members displayed, keeping momentum on critical advocacy and scientific advances. Wishing you a happy #LabWeek2021

Shoutout to all #LabProfessionals #pathology superheroes for doing what it takes, for going that extra mile, for being there for our patients @MDAndersonNews #LabWeek2021

#MicroRounds (Day 844): For #LabWeek2021, #WhyClinMicroMatters with a great catch by a clinical microbiologist: Gram stain looks mixed, with diff shapes, stains. But it's NOT! Acinetobacter baumannii ("A-bomb") is G(-) but retains the stain, can look G+ #ASMClinMicro #IDTwitter


We love our @MontefioreNYC @EinsteinMed #Pathology #HealthcareSuperheroes!!!! 💖🔬🩺🌈🥇🎉 #LabWeek2021 #MontefioreProud #EinsteinStrong @Pathologists @ASCLS #PathTwitter




#MicroRounds (Day 847): for #LabWeek2021 #WhyClinMicroMatters and why techs matter! Pleural fluid w/ mixed bugs. Enterococcus faecalis (~99% isolates Ampicillin S) was Amp R. Huh? Tech knew something was off, went looking: mixed w/ resistant E. faecium! #ASMClinMicro #IDTwitter

Love this picture. Time to give medical laboratory scientists the credit they deserve As doctors, we can't work without them Covid has finally shown the world how important they are Big shout out to medical lab staff! #LabWeek2021 #MedicalLaboratoryProfessionalsWeek #NHS

“I work in a clinical laboratory.” (1/2) What people think (picture) #LabWeek2021 #MedicalLaboratoryProfessionalsWeek #MedicalLaboratoryScientist #Lab4Life #IamASCLS #ASCP

As part of #LabWeek2021 the @Pathology_URMC is having #CrazySockDay. These are the craziest socks I have. Not much to look at. The crazy thing about them is that I stole them from my father in the mid 60's. I wore them on the Appalachian Trail during Spring Break 1971.


#MicroRounds (Day 848): A last #WhyClinMicroMatters to round out #LabWeek2021. Bordetella pertussis/parapertussis PCR test. Sample flagged positive for B. pertussis. But a great tech saw the odd amplification curve & low fluorescence. A real positive? #ASMClinMicro #IDTwitter

Here's the Sacred Heart Micro Lab's contribution to our #LabWeek2021 festivities: the candy bar "C. the Diff-erence" challenge. Candy bars, repackaged (& a bit melted) in stool containers. Reportedly some people are too grossed out to play. 💩😆#WhyClinMicroMatters #IAmClinMicro


AACC members have worked tirelessly to educate and influence policymakers about COVID-19 and lab testing. Their hard work on congressional briefings, letters to congress and regulators, and meetings with lawmakers all improved patient care. #LabWeek2021 ow.ly/O2rh50EslUa

#MicroRounds (Day 843): For #LabWeek2021, I'm highlighting #WhyClinMicroMatters with great catches by techs. Fungal culture. Superficial source, lots of Penicillium. But suspicious tech looks behind it to find… Coccidiodes spp.- a serious invasive mold #ASMClinMicro #IDTwitter



What do laboratory medicine professionals do? AACC volunteer leaders have been spreading the word through multiple media appearances and videos explaining essential knowledge to consumers and clinicians on understanding COVID-19 testing. #LabWeek2021 ow.ly/tera50Eu9li

I am a clinical microbiologist because this career allows me to combine my clinical & basic science interests to impact patient care every day. Best yet, every day in lab is different with its own excitement. #WhyClinMicroMatters #IAmClinMicro #LabWeek2021

It's Medical Laboratory Professionals Week, and my work is celebrating with games, contests, and prizes! The coloring competition is where I hope to shine. Now how to make my entry stand out...? #LabWeek #LabWeek2021



Here's to the medical laboratory professionals—the unsung pandemic heroes. #LabWeek #LabWeek2021 ow.ly/oDch50EtttN
Pictured: the lab enjoying the treats (and accompanying emotional support that comes from recognition) during #LabWeek2021.

CelebrateLAB W. Africa, the Annual Professional Meeting of Laboratory Professionals, Researchers, Policy Makers, Regulators and Highlighting Diagnostics Across W. Africa. For more on CLWA visit: celebratelab.org. #knowledgesharing #LaboProfessionals #labweek2021

Thank you @MedicalLabLadyG for all your support and friendship! Just found it! It was an fun and amazing #Labweek2021
We want to send a big thanks to @TheRealDeanCain for helping us celebrate lab week with an awesome video thanking lab professionals for their hard work. Hope everyone had a great lab week! View video here: bit.ly/3gAj5If #LabWeek2021 bit.ly/3gAj5I

SU is prepared to meet the demand for lab professionals with its competitive Medical Laboratory Science program. SU’s 2021 MLS graduates enter the profession during a critical period in health care. Learn more: ow.ly/7WlA50EAkde #ThankALaboratoryHero #LabWeek2021

#TBT to seven days of creativity, collaboration and physically distanced fun at #LabWeek2021! Thank you to our Dynacare #HealthcareHeroes and to the medical laboratory professionals all around the world for the important work you do each and every day. #MedLabThx

#TBT : 7 jours de créativité, collaboration et plaisir en distanciation sociale à l’occasion de la Semaine du laboratoire médical. Merci à nos #HérosDeLaSanté et aux professionnels de laboratoire médical partout sur la planète pour tout ce que vous faites. #LabWeek2021 #MedLabThx

In honor of #labweek2021, Qvella celebrates all Medical Laboratory Professionals who play a vital role in health care and patient advocacy. Qvella extends a special Thank You to the Lab Professionals currently testing the FAST-Prep™ PBC System. qvella.com

Laboratory detectives at Allen County Regional Hospital celebrated #LabWeek2021 last week with a "Mystery Diagnosis" workshop. Fellow staff members were invited into the lab to learn more about the work of our laboratory team and how they impact patient care.




Proud and honored to celebrate #Labweek2021 with our Reimbursement team. The Reimbursement team advocates for all our breast cancer patients by ensuring that their claims are filed on a timely basis, clean and accurate, and following all applicable rules and regulations.

While #LabWeek2021 may have passed, we're still celebrating our laboratory team at @nationwidekids! Donning coats ... and sometimes capes this team is truly made up of superheroes!

In the 2nd installation of our #LabWeek2021 podcast series, we chat to Dr Dwaine Vance, COVID Lab Manager. At the very start of the pandemic, as Molecular Specialist, Dr Vance was called upon to play a key role in Randox’s testing efforts. youtube.com/watch?v=x9OLoO… #wearerandox
youtube.com
YouTube
Randox Lab Week 2021 Podcast Series Episode 2: Dr Dwaine Vance
This week we recognized the vital contribution of our lab & colleagues to the scientific & medical communities. IHMA celebrated our hardworking staff with a week of fun activities & themed days. See our “Lab Rats” after the Lab Rat Toss event! No rats were harmed🙂#LabWeek2021


بمناسبة أسبوع مهنيي المختبرات الطبية ٢٠٢١، نشكر أبطال المختبرات على العمل الاستثنائي خلال فترة الجائحة، نحن فخورون بكم. #LabWeek2021 #LabWeek

This past year, the fight against COVID-19 brought the importance of lab medicine professionals into the spotlight. AACC is proud of the hard work and ingenuity our members displayed, keeping momentum on critical advocacy and scientific advances. Wishing you a happy #LabWeek2021

Shoutout to all #LabProfessionals #pathology superheroes for doing what it takes, for going that extra mile, for being there for our patients @MDAndersonNews #LabWeek2021

We love our @MontefioreNYC @EinsteinMed #Pathology #HealthcareSuperheroes!!!! 💖🔬🩺🌈🥇🎉 #LabWeek2021 #MontefioreProud #EinsteinStrong @Pathologists @ASCLS #PathTwitter




It’s #LabWeek2021 in the US but a huge thank you to healthcare scientists and laboratory professionals wherever you are for the vital work you do. Wearing my #LabWeek pins with pride - many thanks to my friend CBA for sending them to me.



“I work in a clinical laboratory.” (1/2) What people think (picture) #LabWeek2021 #MedicalLaboratoryProfessionalsWeek #MedicalLaboratoryScientist #Lab4Life #IamASCLS #ASCP


AACC members have worked tirelessly to educate and influence policymakers about COVID-19 and lab testing. Their hard work on congressional briefings, letters to congress and regulators, and meetings with lawmakers all improved patient care. #LabWeek2021 ow.ly/O2rh50EslUa

“The Outliers” RT-PLMI Path Cup Team showing their #LabWeek2021 pride! 🙂🔬🧬🦠🧪🧫 @sm_ashour @roshanpath @PeterMannion7 @FrozenSections @KateKeiling @JasmineShen11 @CCFPathRes @CLEClinicLabs

#MicroRounds (Day 844): For #LabWeek2021, #WhyClinMicroMatters with a great catch by a clinical microbiologist: Gram stain looks mixed, with diff shapes, stains. But it's NOT! Acinetobacter baumannii ("A-bomb") is G(-) but retains the stain, can look G+ #ASMClinMicro #IDTwitter


#MicroRounds (Day 843): For #LabWeek2021, a Gram stain from a brain abscess, pt w/ hx of dental work. Do you see anything? An example of #WhyClinMicroMatters: tech with great eyes called fusiform Gram neg rods. Grew Fusobacterium spp. #ASMClinMicro #IDTwitter #IAmClinMicro


We are celebrating #LabWeek2021! Please join us in recognizing our heroes in lab coats 🔬🧫🥼🧪 Read more: dlmp.uw.edu/news/article/c… #LabWeek #ASCPLabWeek21

#MicroRounds (Day 847): for #LabWeek2021 #WhyClinMicroMatters and why techs matter! Pleural fluid w/ mixed bugs. Enterococcus faecalis (~99% isolates Ampicillin S) was Amp R. Huh? Tech knew something was off, went looking: mixed w/ resistant E. faecium! #ASMClinMicro #IDTwitter
As part of #LabWeek2021 the @Pathology_URMC is having #CrazySockDay. These are the craziest socks I have. Not much to look at. The crazy thing about them is that I stole them from my father in the mid 60's. I wore them on the Appalachian Trail during Spring Break 1971.

#MicroRounds (Day 848): A last #WhyClinMicroMatters to round out #LabWeek2021. Bordetella pertussis/parapertussis PCR test. Sample flagged positive for B. pertussis. But a great tech saw the odd amplification curve & low fluorescence. A real positive? #ASMClinMicro #IDTwitter

#MicroRounds (Day 843): For #LabWeek2021, I'm highlighting #WhyClinMicroMatters with great catches by techs. Fungal culture. Superficial source, lots of Penicillium. But suspicious tech looks behind it to find… Coccidiodes spp.- a serious invasive mold #ASMClinMicro #IDTwitter

Something went wrong.
Something went wrong.
United States Trends
- 1. Cheney 35.8K posts
- 2. #AcousticPianoSnowGlobe 1,902 posts
- 3. Nano Banana Pro 13.5K posts
- 4. First Take 42.4K posts
- 5. #NXXT_NEWS N/A
- 6. #TSTheErasTour 1,565 posts
- 7. Trump and Vance 27K posts
- 8. FINAL DRAFT FINAL LOVE 323K posts
- 9. #LoveDesignFinalEP 296K posts
- 10. Cam Newton 1,910 posts
- 11. SEDITIOUS BEHAVIOR 9,612 posts
- 12. Stephen A 35.3K posts
- 13. Husqvarna N/A
- 14. Bush 48.4K posts
- 15. Nnamdi Kanu 165K posts
- 16. Godzilla 21.3K posts
- 17. Haymitch 16.5K posts
- 18. #WeekndTourLeaks N/A
- 19. Pablo 66.5K posts
- 20. YOYOK N/A




































